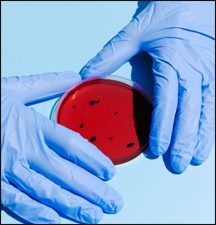

“I am not as calm as I should be even tho' I've read Isaiah 43 and Psalm 91.”
"Do not be afraid, for I am with you.
I will gather you and your children from east and west."
Just reading something and knowing that we SHOULD be calm and collected is of course not what is needed. We need such a close connection to Jesus that we no longer fear the things that can happen to us here on earth (Corona virus included). That is easier said than done, but it is something that we can ask God to do for us.
I was just thinking of the magnet illustration I use often to help me understand what is happening to me. Jesus said that He is drawing ALL people to Himself by His love as seen in light of the cross (John 12:32), so envision Jesus as being The Super Magnet, and us as being a steel ball bearing, or chunk of steal. That means that both you and I are being drawn to Him. We cannot change that power, but we can resist it by holding on to the things around us like steel can become attached by rust to the barrel. Things can keep us from being drawn to Him, but if we ask Him to help us to submit to His drawing, and help us let go of things around us then we will be drawn closer and closer to Him.
I envision us as being in a barrel of polluted, cold honey though, and we are sitting at the bottom with Jesus above. This world is polluted by sin, with things like the COVID-19 virus making it hard for us to get closer to Jesus even though we are constantly being drawn by Him, but if we ask Him to continue to draw us then we will continue our upward journey even though it may be slow. It may even seem as if nothing is happening, but trust Him! (Ask Jesus to help you around all obstacles.)
One thing that most people don't know though is that when a steel ball is being drawn by a SUPER strong magnet (such as an MRI machine at a hospital) if there is resistance the ball will begin to heat up. If it was stuck in cold, solid honey the magnet would begin to heat up that ball which in turn would heat up the honey around it and it would progress upwards towards the magnet easier. As we are drawn by Jesus (the Super Magnet) our surroundings will begin to change, allowing us to move towards Him.

As we are drawn upward we are also getting closer to Jesus, and like a chunk of steel as it gets closer to a magnet becomes magnetized, we will begin to become more and more like Jesus on the inside. We will become more attractive to others, and as others are drawn to us we all are encouraged by those around us and continue the journey upward together. And together we are stronger and less likely to slip and fall than if we were going it alone.
So my prayer for you is that we will do better at connecting with people who love Jesus by way of social media, and keep our focus on Jesus and His love. Remember, Keep the Main Thing the Main Thing. After all, it’s His love that is drawing us up out of the mess we are in.
God allows things like the Coronavirus (bad things happening to good people) because they help us to refocus on what is really important. Bible prophecy is there to prove that God is in control, that He is real, but our focus should be on Jesus, not on a timeline. Jesus wants only the best for us, and He wants us to trust Him, but again, that is easier said than done.
The problem is, we cannot begin to really trust Jesus until we get to know Him better, any more than we can trust the person next door until we get to know them. It takes time and effort, but if we ask Jesus to help us focus on what is important (Him) then He will help us build that trust.
Just the act of asking Jesus for help is the beginning of trust. It proves that we trust Him enough that we are asking for and wanting HIS help. That’s where it all begins.
Great and Holy Father in Heaven, we are asking for Your help. We are asking that You help us to trust You totally. We believe in Your existence, and we also believe in Your way of doing things, so continue to draw us up and out of the mess sin has caused in this world. We have a natural tendency, a real desire, to hang onto things that really are not important, and so we are asking that You will help us to WANT to be done with anything that will keep us from being drawn to you.
Thank You for hearing and for answering this prayer! Thank You for letting Jesus come so that we can live life to the fullest. (Jesus, thank You!!! We love life!)
We ask this in the Holy name of Jesus, amen.
Stay safe physically, mentally, and especially spiritually. Refocus on Jesus and His love for you. Everyday build your trust in Him by reading your Bible. And don't forget to ASK!
EVERYDAY, ASK!